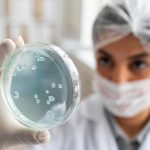
legionella gdzie w polsce

W wieku 57 lat zmarła nagle uwielbiana przez słuchaczy z Katowic reporterka i dziennikarka tamtejszej rozgłośni radiowej. Pracownicy radia są pogrążeni w smutku, bo nic nie wskazywało na to, aby miało dojść do tragedii.
Nie żyje legenda katowickiego dziennikarstwa radiowego. Miała 57 lat
Niepowtarzalny głos i stworzona do pracy w radiu osobowość. Pracownicy Radia Katowice są zdruzgotani informacją o śmierci swojej koleżanki Agnieszki Strzemińskiej. Zmarła ona nagle w piątek 25 sierpnia w wieku zaledwie 57 lat.
– Nagle i zupełnie za wcześnie zmarła nasza redakcyjna koleżanka, wybitna dziennikarka radiowa, Agnieszka Strzemińska. Radio było jej wielką życiową przygodą i miłością. Do rozgłośni przy Ligonia 29 Agnieszka przyszła pracować 33 lata temu. Przez lata dała się poznać jako doskonała dziennikarka i prezenterka – czytamy na profilu rozgłośni na Facebooku.
– Relacjonowała zarówno wydarzenia sportowe, jak i kulturalne. Najbardziej lubiła pracować w terenie. Jej audycje: „O czym milczy historia?” czy „Książki mojej młodości” od lat mają wierne rzesze słuchaczy – napisali koleżanki i koledzy z radia.
Agnieszka Strzemińska – jak napisali jej przyjaciele z pracy – dbała o poprawność językową. W marcu została członkinią Rady Języka Polskiego przy prezydium Polskiej Akademii Nauk. Na antenie Radia Katowice w audycji „Słowa i słówka” edukowała zarówno słuchaczy, jak i nas, redakcyjnych kolegów, jak poprawnie mówić. Dziennikarka osierociła syna Wiktora.